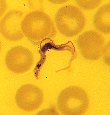

(diplomonad) |
BASAL EUKARYOTA
Condensed greatly from Tree of Life for taxa covered in Zool250
|

(foraminifera) |
=================== Prokaryotes
<<===|
| ==D=========== Diplomonads (P/B phylum Metamonadida, zooflagellate, Giardia)
==E==|
| ======== "radiolaria" (P/B phyla Acantharia; Heliozoa); actinopod sarcodine
==Mt==|
======== Granuloreticulosa (foraminifera); rhizopod rhizopod sarcodine
|
================================== TO CROWN EUKARYOTES ===>
TRAITS MAPPED ON ABOVE TREE: